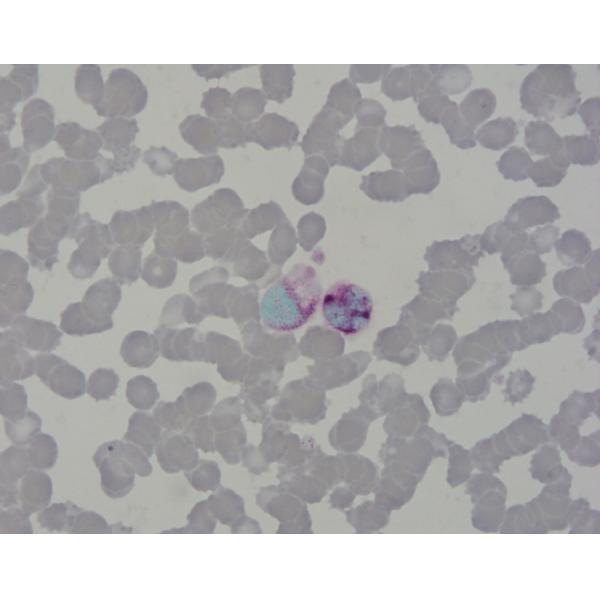

| Sign In | Join Free | My benadorassociates.com |
|
| Categories | Cytology Stains |
|---|---|
| Brand Name: | Baso |
| Certification: | IVDR Class A; ISO 13485:2016 |
| Applicable Departments: | Hospital,Clinic,Research Institution |
| Place of Origin: | China |
| MOQ: | 1 Box |
| Price: | Negotiated |
| Payment Terms: | T/T |
| Packaging Details: | Paper box |
| Delivery Time: | To be confirmed |
| Supply Ability: | To be confirmed |
| Company Info. |
| Baso Group |
| Verified Supplier |
| View Contact Details |
| Product List |
Acid Phosphatase Stain (ACP) 6 Tests Baso Stains Clear Colourful Stains
What is Acid Phosphatase Stain (ACP)?
Acid Phosphatese stain is based on diazotization-coupling principle. At pH5.0, Acid Phosphatase hydrolyzes Naphthol AS-BI Phosphoric Acid and releases Naphthol AS-BI to mix with diazonium salt and form colored precipitate in cytoplasm.
Stain Results
Mauve granules are positive.
Packaging specification
Product Name | Ref # | Specification |
Acid Phosphatase Stain (ACP) 6 Tests | BA4118A | 6Tests/Kit |
|